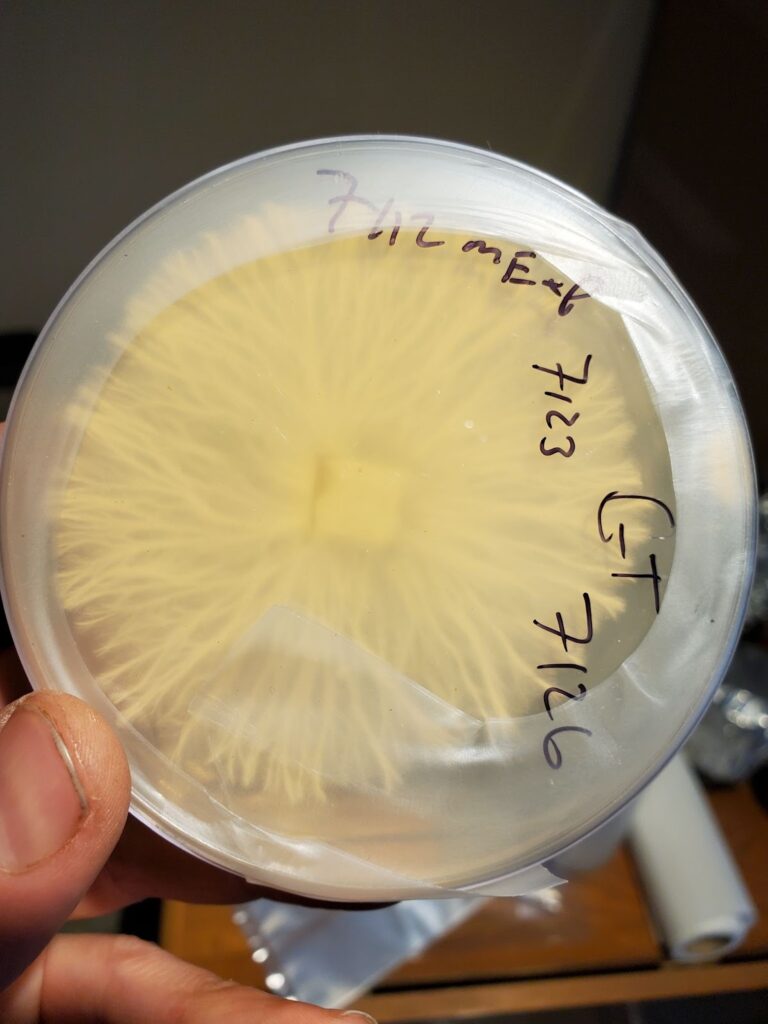
Rhizomorphic mycelium
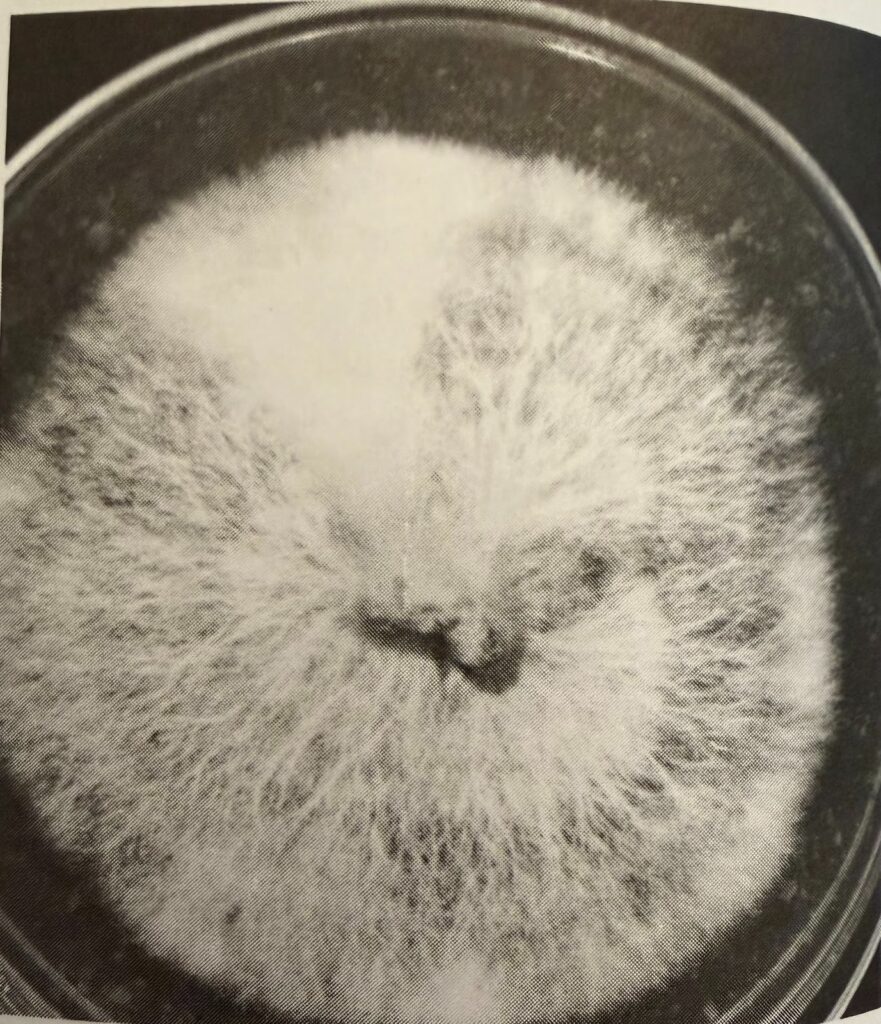
Rhizomorphic growth with a sector of tomentose mycelium

Rhizomorphic mycelium on agar by Mycology Men
Rhizomorphic mycelium and tomentose mycelium sectors are what you see growing on agar plates. They are distinct patterns that are literally the genetics of the mycelium. Strains are expressed visually differently. You may see differences in texture, density, growth speed, and tomentose or rhizomorphic patterns. Analyzing all of the visual clues allows mycologists to isolate specific sectors that are ideal for their goals. This can help you create a line of genetically ideal liquid cultures.
Rhizomorphic mycelium appears strandy (source). You can see distinct strands that make up the mass of rhizomorphic growth. Tomentose mycelium appears cottony. Rather than individual strands like rhizomorphic mycelium, tomentose mycelium is like a big fluffy mass. But which is better for growing mushrooms? We will answer that question and more during this article.
Rhizomorphic mycelia with a cottony sector (up top, slightly left)
(The Mushroom Cultivator, Stamets and Chilton, page 32)
Tomentose mycelium is considered by many to be inferior to rhizomorphic mycelium growth. The cottony and cloud-like sectors can be less aggressive during colonization which means slower growth speed.
With that being said, it does not mean that cottony mycelial sectors are weak or unusable. Tomentose sectors are even expected for some strains of mushrooms like oysters and reishi. They are also more likely to occur when the agar is low on nutrients or in a high humidity environment.
The main thing to look out for is cottony sectors when you were expecting rhizomorphic sectors. This could be an indicator of a number of things. First off, it could mean unstable genetics which is not ideal. It could also mean your mycelium is under stress from the environment. That could be a lack of nutrients, too much humidity, or temperature swings. Finally, it could also be an early indicator of contamination. Regardless of why a cotton sector shows up, if you are working with a strain that is otherwise rhizomorphic, you should be concerned.
So, to answer the question, “is tomentose mycelium bad”, the answer is: not always, but it can be concerning.

Rhizomorphic mycelia
(The Mushroom Cultivator, Stamets and Chilton, page 32)
Many find that rhizomorphic mycelium sectors are more suitable for their goals. The strandy, root-like sectors of mycelium are generally more aggressive during colonization. Not only that, but it could be an indicator of higher yields (not guaranteed). Rhizomorphic mycelium tends to adapt well to the grains and bulk substrate you will eventually be growing your mushrooms in.
So, to answer the question, “is rhizomorphic mycelium good”, the answer is: mostly yes, but it is not a guarantee of superior genetics.
Sectors of mycelium on agar are expressions of that strain's genetics. Different sectors are different genetics expressing themselves. This is why people use agar; it allows them to isolate specific sectors with traits they find appealing.
But it is important to remember that rhizomorphic mycelium and tomentose mycelium are not guaranteed indicators of a healthy and viable sector. These are great clues, but there are many other factors at play. For example, micro changes in the agar environment could lead to differences between sectors.
Stability, stability, stability. That is what you are looking for in an ideal sector. As we discussed above, many prefer rhizomorphic mycelium to tomentose mycelium, but just because you have a rhizomorphic sector, does not mean it is a good candidate for culture selection. What you really want are stable genetics. This means consistent growth direction, contaminate-free edges, and strong recovery after you have transferred a sector. If there are abrupt texture changes, wet-looking sectors, or uneven growth, you are probably looking at unstable genetics.
Cottony growth (tomentose mycelium) is not all bad! Sometimes it is even exactly what you want. Certain strains like oyster and reishi naturally grow tomentose. Cottony sectors are also known to be contaminant resistant. Now, we just want to be very clear here. Cottony growth can be contaminant resistant, but not because it has stronger genetics, but because cottony growth thrives in the same environment that bacteria and mold do not thrive. You will see tomentose mycelium commonly in environments with high humidity and low oxygen - this just happens to be the exact environment that mold and bacteria dislike. This is part of the reason why many commercial grows look for cottony agar sectors.
Find an agar plate with clean sectors, no contamination, and active growth. You don’t want a plate that is too young or too old. Plates that are too young have not fully developed the different sectors. Plates that are too old may have already exhausted their growth potential. The sweet spot is usually within 3-7 days after inoculation.
First off, sterilize your scalpel with a flame. Make it red hot then let it cool. Now, cut the agar plate from the leading edge of the sector you are targeting. By leading edge, we mean the youngest and therefore most active edge. It is where the mycelium is expanding into new territories.
Cut a wedge about 4mm wide. Transfer the wedge to a fresh agar plate and place it mycelium-side down.
It is best practice to avoid the center of the colonization because this is usually where the older mycelium lives. It will be harder to recover after transfer so it is best to just avoid it all together. It is also more difficult to tell the difference between sectors at the center so you might end up with a mixed bag.
You will never remember all the factors that made you choose that sector unless you practice extensive labeling. Trust us, it will save you headaches down the line. Important notes to label include, the plate ID (ex. Lion’s Mane Plate A), the sector ID (ex. Rhizomorphic leading edge), date you transferred the sector, and any notes you think may be useful (ex. fast growth).
Once you have let your transferred sector expand on a new plate, you can test a wedge in a grain jar. This will help you determine things like the colonization speed. If you are hunting genetics and transferring multiple sectors to multiple clean plates, then run the grain test with identical grain setups. This means using the same grains in the same jars with the same preparations and the same amount of mycelium. Since the only variable is the mycelium you used, this can help you find the best of the best.
Now we are really getting into the part when we find which sectors are worth continuing with. You should track how long it takes for full colonization of grains, how even was the colonization, and visual cues to determine health (ex. no wet spots or weird colors).
It is important to remember that fast growth does not automatically mean that it is the best sector. If it grows fast, but inconsistently, that could mean the genetics are unstable. In most situations, it is better to value consistency over speed. This is what we mean when we say that cottony sectors are not always bad. If they perform well in grain, then stick with them!
Once you have determined which grain tests you want to move forward with, move them to bulk substrate and run the same comparison. Record how long it takes for them to pin, how much you yield, and the quality of what you yield.
Once you have gone through all of this and have finally chosen a sector you want to keep and continue to use, you have to preserve it! Keep the master plate in cold storage, wrapped tightly to avoid contamination. It can also be life saving to make backup plates.